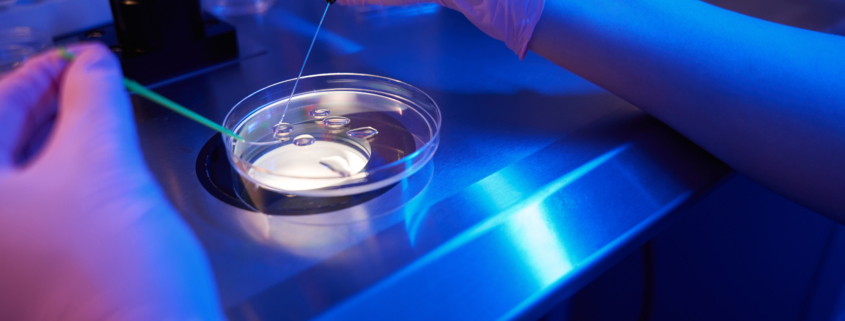

Teaching the Truth About IVF
The practice of in vitro fertilization (IVF) is so anti-life it astonishes people who believe it is a positive and compassionate scientific breakthrough enabling infertile couples and others to have children. Yet even as IVF grows in popularity, including support from the Trump administration, most secular schools and universities refuse to teach the truth about it. Catholic educators, then, must be public witnesses to the evils of IVF, enlightening their students about its dangers while standing firm and refusing to cooperate with IVF coverage in student and employee health plans.
How would any objective person evaluate a medical procedure that killed or left in suspended animation over 90 percent of its patients? IVF generally results in the live birth of only approximately 10 percent of the embryos conceived using this technique. “The IVF industry treats human beings like products and freezes or kills millions of children who are not selected for transfer to a womb or do not survive,” says the U.S. Conference of Catholic Bishops.
The Catechism of the Catholic Church in paragraphs 2376-2378 makes it abundantly clear that IVF and similar artificial reproductive technologies are gravely immoral and “dissociate the sexual act from the procreative act.” The Church affirms that children have the right to be respected as a person from the first moment of conception/fertilization and not to be treated like an object.
A pro-life philosophy is one that affirms all human beings must have their right to life respected from the first moment of their lives. It is nonsensical to call IVF “pro-life,” as a few groups do, because it helps some couples bear children. Yes, assisting people to have babies is pro-life, but not when the price is the deaths of multiple children for every one that is born alive. Would one call a medical intervention that prevented the deaths of some sick patients “pro-life,” if it killed several people for each person that it saved?
The procedure euphemistically known as “pregnancy reduction” is obviously anti-life. Since IVF-conceived embryos frequently do not implant and develop, it has been common for technicians to put three or more embryos in the woman. (Thankfully, in recent years the trend has been towards the transfer of fewer embryos.) If, however, multiple embryos survive and go forward, IVF doctors often counsel their clients to abort all but one of the babies, in order not to have more than the one desired child and to reduce the increased health risks attendant on twin, triplet, etc. pregnancies. Eugenics also comes into play, since the doctor uses an ultrasound to guide the fatal needle into the hearts of the fetuses deemed the least healthy. One might think that a couple seeking to overcome infertility would be happy to welcome twins, but the most common “pregnancy reduction” abortions are the killing of one preborn child to prevent the birth of twins.
Some argue they could do IVF without conceiving large numbers of embryos, or they could transfer all of their children to the womb and avoid intentionally killing any of them. Would this be “pro-life” IVF? It certainly reflects a pro-life attitude, but it is not pro-life to expose one’s children to tremendous risk of death through IVF procedures. At each stage in the process, these tiny human beings are at risk. Their conception and early life in the artificial atmosphere of a lab results in some deaths. Freezing and thawing them for transfer kills many. The embryos frequently fail to implant in the womb or are fatally miscarried at higher rates than normal pregnancies. Children conceived through IVF are at greater risk of fatal and non-fatal genetic anomalies and health problems. Thus, beyond the ethical violations inherent in causing conception to happen outside of the mother’s body, IVF is also incompatible with the pro-life parental concern that refuses to intentionally place one’s future children in harm’s way.
The instruction from the Congregation for the Doctrine of the Faith, Dignitas Personae, sums up the anti-life nature of IVF: “The blithe acceptance of the enormous number of abortions involved in the process of in vitro fertilization vividly illustrates how the replacement of the conjugal act by a technical procedure—in addition to being in contradiction with the respect that is due to procreation as something that cannot be reduced to mere reproduction—leads to a weakening of the respect owed to every human being. Recognition of such respect is, on the other hand, promoted by the intimacy of husband and wife nourished by married love.”
My wife and I suffered from infertility until the conception of our daughter Therese, over eight years into our marriage. We explored and pursued many treatments for infertility. IVF, however, never tempted us because of our Catholic faith and our deep pro-life convictions. Couples faced with infertility show the sacrificial love typical of good parents when they refuse to agree to the “quick fix” of IVF that practically guarantees some of their offspring will die in pursuit of a slim chance of a “babe in arms.” Children and parents deserve better than IVF. Thankfully, ethically sound restorative reproductive medicine is available and helps couples fulfill their dream of parenthood, without incurring the guilt of sacrificing lives to attain the blessing of a family.
Joseph Meaney, PhD, KM
Past President and Senior Fellow of The National Catholic Bioethics Center